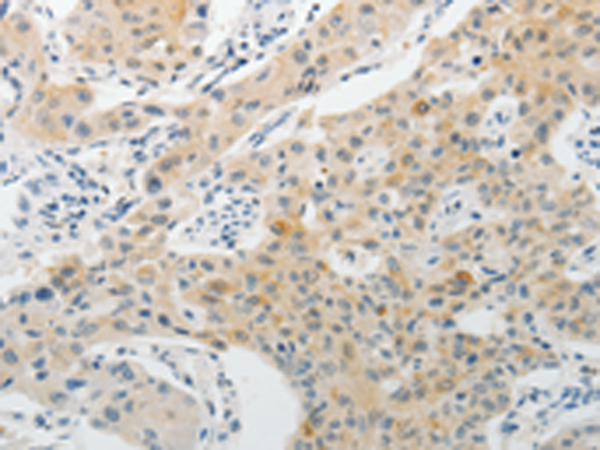
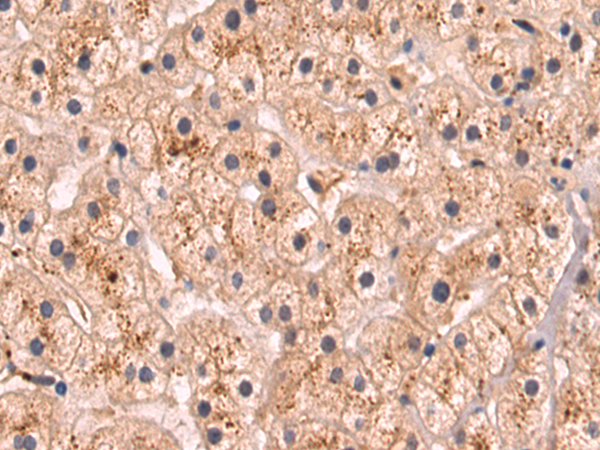
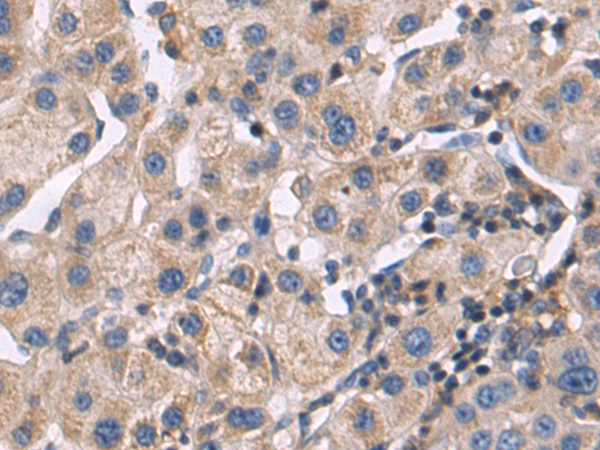
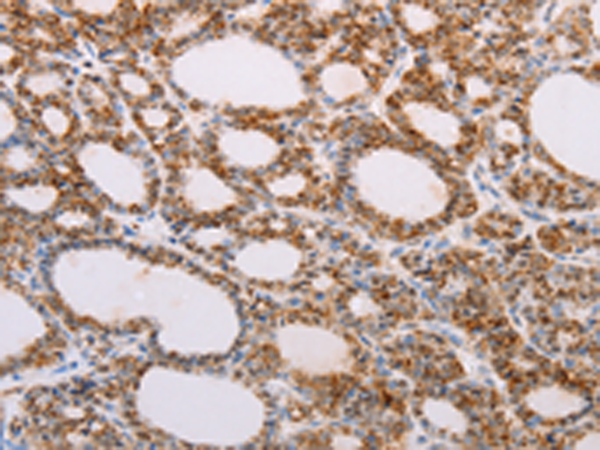

-
分类: 科研抗体货号: P07524别名: PAR6; PAR6C; TAX40; PAR-6A; TIP-40; PAR6alpha应用: IHC反应种属: Human, Mouse, Rat
-
分类: 科研抗体货号: P07518别名: PAD; PAD4; PDI4; PDI5; PADI5应用: IHC反应种属: Human
-
分类: 科研抗体货号: P07537别名: PEK; WRS; PERK应用: WB,IHC反应种属: Human, Mouse, Rat
-
分类: 科研抗体货号: P07523别名: DLD; 2.19; XAP-7; DXS560S应用: WB,IHC反应种属: Human, Mouse
-
分类: 科研抗体货号: P07517别名: S6K, PS6K, S6K1, STK14A, p70-S6K, p70-alpha, p70(S6K)-alpha应用: WB,IHC反应种属: Human, Mouse, Rat
-
分类: 科研抗体货号: P07535别名: serpin family F member 1,OI6; OI12; PEDF; EPC-1; PIG35应用: WB反应种属: Human, Mouse
-
分类: 科研抗体货号: P07522别名: PAK7应用: WB,IHC反应种属: Human, Mouse, Rat
-
分类: 科研抗体货号: P07516别名: P73应用: WB,IHC反应种属: Human, Mouse
-
分类: 科研抗体货号: P07534别名: PDEF; bA375E1.3应用: WB,IHC反应种属: Human, Mouse
-
分类: 科研抗体货号: P07555别名: RAMP4应用: IHC反应种属: Human, Mouse, Rat

鄂公网安备42018502007531号
鄂公网安备42018502007531号

